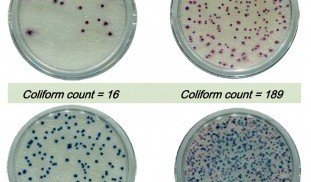
food poisoning Comapct_Dry_EC_Ecoli&Coliforms.jpg

-
-
ประเภทการทดสอบอาหาร
-
การตรวจอาหารก่อภูมิแพ้ food allergens
-
การตรวจเชื้อก่อโรคในอาหาร food borne pathogens
-
การตรวจสุขอนามัยความสะอาด Rapid Hygiene Monitor
-
การตรวจสารพิษไมโคทอกซิน Mycotoxins
-
การตรวจระดับสารกำจัดศัตรูพืช Pesticides Herbicides
-
การตรวจสารปฏิชีวนะตกค้าง antibiotics & additives
-
การตรวจสารไนโตรฟลูรานเมตาโบไลท์ Nitrofurans
-
การตรวจสารเร่งกลุ่มเบต้าอะโกนิสต์ B-agonist
-
การตรวจแยกสายพันธ์จากเนื้อ animal species
-
การตรวจอาหารปลอมปน food adulteration
-
การตรวจสารพิษจากสาหร่าย algal toxins
-
การตรวจสารโลหะหนัก heavy metals
-
การตรวจสารเคมีจากอุตสาหกรรม industrial chemicals
-
การตรวจพืชจีเอ็มดัดแปลงพันธุกรรม GMOs
-
การตรวจสารปนเปื้อนต่างๆ contaminants
-
การตรวจส่วนประกอบอาหาร food constituents
-
-
ลิงค์ผลิตภัณฑ์
-
สาระ Knowledge
-
กฎระเบียบ ข่าว
-
เทคนิคการวัดทดสอบ
-
ประวัติ achieved
-
การฝึกอบรม Training
-
สินค้าปรับเปลี่ยน
-
งานแสดงสินค้า
-
การประกัน Warranty
-
วิธีการสั่งซื้อ
-
-
สมัครรับข่าวสาร
-
-
-
-
แบบฟอร์มติดต่อกลับ
Compact Worth Corp.
บริษัท คอมแพทค์ เวิร์ธ คอร์ปอเรต จำกัด เป็นผู้จัดจำหน่ายสินค้าเครื่องมือทางห้องปฏิบัติการ เครื่องตรวจวัดและชุดสอบทางวิทยาศาสตร์ในสาขาต่างๆ โดยเฉพาะในด้านเกษตรอาหารและสิ่งแวดล้อม จากโรงงานผู้ผลิตชั้นนำทั่วโลก ด้วยประสบการณ์ดำเนินการนานกว่า10ปี เพื่อสนับสนุนการปฏิบัตงานดำเนินการของท่านให้สำเร็จลุล่วงไปเป็นอย่างดี Compact Worth Corporate Co., Ltd. is a distributor of laboratory equipment, scientific instruments and test kits in various fields especially in agriculture, food and the environment from world-class manufacturers, with more than 10 years of operating experience. We need to support the implementation of your operations to be successful as well.
food poisoning
Visitors: 190,954